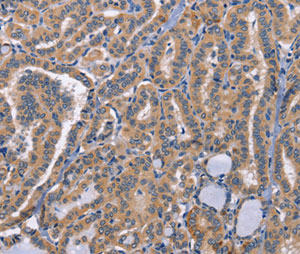
product-image-AAA305702_IHC13.jpg

CD48 active protein
CD48 Protein, Human, Recombinant (His Tag)
Gene Names
CD48; BCM1; BLAST; hCD48; mCD48; BLAST1; SLAMF2; MEM-102
Purity
>95% as determined by SDS-PAGE
Synonyms
CD48; N/A; CD48 Protein, Human, Recombinant (His Tag); Human CD48/SLAMF2/BCM1 Protein (His Tag); BCM1 Protein, Human; BLAST Protein, Human; Blast-1 Protein, Human; BLAST1 Protein, Human; hCD48 Protein, Human; mCD48 Protein, Human; MEM-102 Protein, Human; SLAMF2 Protein, Human; CD48 molecule; CD48 active protein
Host
HEK293 Cells
Purity/Purification
>95% as determined by SDS-PAGE
Form/Format
Lyophilized from sterile PBS, pH7.4. Normally 5%-8% trehalose, mannitol and 0.01% Tween80 are added as protectants before lyophilization. Please refer to the specific buffer information in the hard copy of CoA.
Sequence
Met1-Ser220
Species
Human
Activity
Measured by its binding ability in a functional ELISA. Immobilized human CD48 at 10ug/ml (100uL/well) can bind recombinant human 2B4/CD244 with a linear range of 0.004-0.4ug/ml.
Endotoxin
<1.0EU per ug of the protein as determined by the LAL method
Predicted N Terminal
Gln 27
Tag
C-His
Protein Construction
A DNA sequence encoding the human CD48 (NP_001769.2)(Met 1-Ser 220) with a C-terminal polyhistidine tag was expressed.
Reconstitution
A hardcopy of COA with reconstitution instruction is sent along with the products. Please refer to it for detailed information.
Preparation and Storage
Samples are stable for up to twelve months from date of receipt at -20 degree C to -80 degree C. Store it under sterile conditions at -20 degree C to -80 degree C. It is recommended that the protein be aliquoted for optimal storage. Avoid repeated freeze-thaw cycles.
In general, recombinant proteins are provided as lyophilized powder which are shipped at ambient temperature. Bulk packages of recombinant proteins are provided as frozen liquid.
They are shipped out with blue ice.
In general, recombinant proteins are provided as lyophilized powder which are shipped at ambient temperature. Bulk packages of recombinant proteins are provided as frozen liquid.
They are shipped out with blue ice.
Related Product Information for CD48 active protein
Background: Cluster of Differentiation 48 (CD48), also known as SLAMF2, BCM-1 and BLAST-1, is a GPI-linked protein belonging to the CD2 subfamily of immunoglobulin superfamily molecules. CD2 and 2B4 (CD244) are known ligands for CD48. CD48 protein is expressed on most lineage-committed hematopoietic cells but not on hematopoietic stem cells or multipotent hematopoietic progenitors. CD48 protein performs biological functions in a variety processes including adhesion, pathogen recognition, cellular activation, and cytokine regulation, and emerges as a critical effector molecule in immune responses.
Product Categories/Family for CD48 active protein
References
Messmer B, et al. (2006) CD48 stimulation by 2B4 (CD244)-expressing targets activates human NK cells. J Immunol. 176(8): 4646-50Milstein O, et al. (2008) Nanoscale increases in CD2-CD48-mediated intermembrane spacing decrease adhesion and reorganize the immunological synapse. J Biol Chem. 283(49): 34414-22.
NCBI and Uniprot Product Information
NCBI GI #
NCBI GeneID
NCBI Accession #
NCBI GenBank Nucleotide #
Molecular Weight
19,429 Da
NCBI Official Full Name
CD48 antigen isoform 1
NCBI Official Synonym Full Names
CD48 molecule
NCBI Official Symbol
CD48
NCBI Official Synonym Symbols
BCM1; BLAST; hCD48; mCD48; BLAST1; SLAMF2; MEM-102
NCBI Protein Information
CD48 antigen
UniProt Protein Name
CD48 antigen
UniProt Gene Name
CD48
UniProt Synonym Gene Names
BCM1; BLAST1; SLAMF2
Customer Reviews
Loading reviews...
Share Your Experience
Similar Products
Product Notes
The CD48 cd48 (Catalog #AAA257929) is an Active Protein produced from HEK293 Cells and is intended for research purposes only. The product is available for immediate purchase. The amino acid sequence is listed below: Met1-Ser22 0. It is sometimes possible for the material contained within the vial of "CD48, Active Protein" to become dispersed throughout the inside of the vial, particularly around the seal of said vial, during shipment and storage. We always suggest centrifuging these vials to consolidate all of the liquid away from the lid and to the bottom of the vial prior to opening. Please be advised that certain products may require dry ice for shipping and that, if this is the case, an additional dry ice fee may also be required.Precautions
All products in the AAA Biotech catalog are strictly for research-use only, and are absolutely not suitable for use in any sort of medical, therapeutic, prophylactic, in-vivo, or diagnostic capacity. By purchasing a product from AAA Biotech, you are explicitly certifying that said products will be properly tested and used in line with industry standard. AAA Biotech and its authorized distribution partners reserve the right to refuse to fulfill any order if we have any indication that a purchaser may be intending to use a product outside of our accepted criteria.Disclaimer
Though we do strive to guarantee the information represented in this datasheet, AAA Biotech cannot be held responsible for any oversights or imprecisions. AAA Biotech reserves the right to adjust any aspect of this datasheet at any time and without notice. It is the responsibility of the customer to inform AAA Biotech of any product performance issues observed or experienced within 30 days of receipt of said product. To see additional details on this or any of our other policies, please see our Terms & Conditions page.Item has been added to Shopping Cart
If you are ready to order, navigate to Shopping Cart and get ready to checkout.